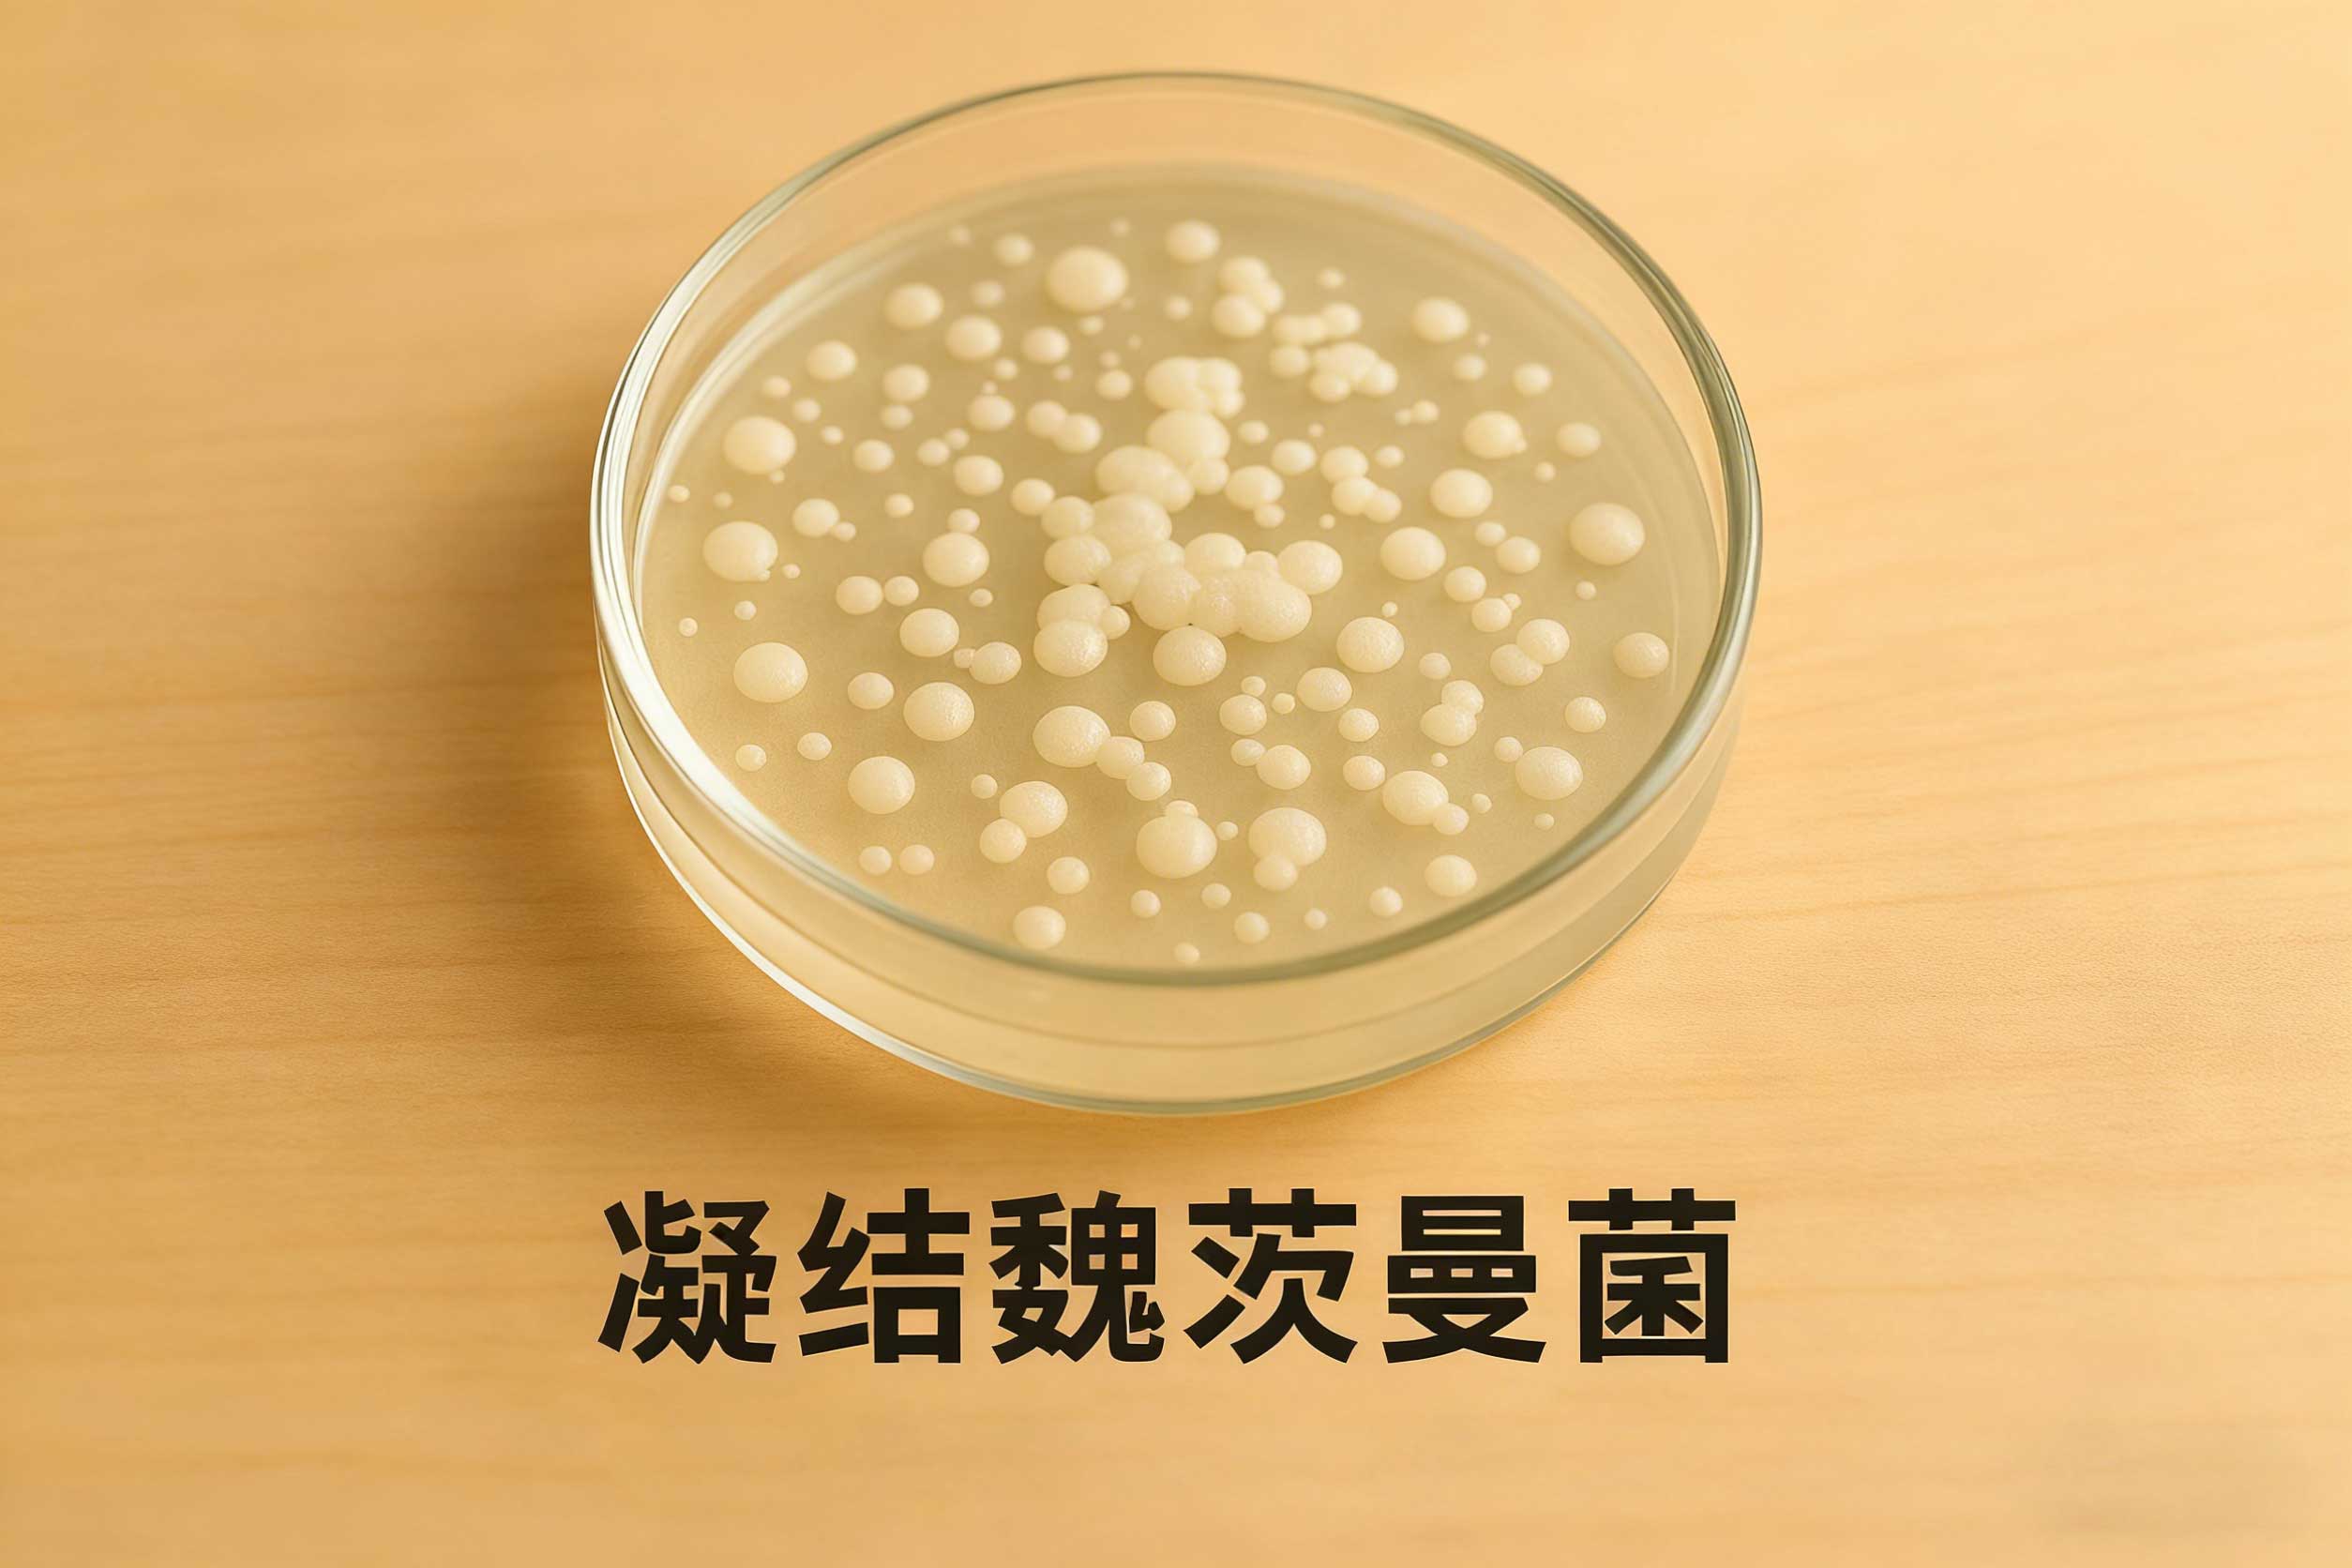

一、它是谁:把“活”带到终点的耐造型选手
“魏茨曼菌”这个名字听着高冷,其实它就是我们熟悉的凝结芽孢杆菌的新名(分类学更新后改称 Weizmannia coagulans)。与许多乳酸菌不同,它能形成坚韧的芽孢——相当于披上“盔甲”:
· 耐热:加工与储存友好,做成固体饮料、小条包不容易被“烘焙气氛”KO;
· 耐酸:穿过胃酸大门的存活率更有保障;
· 到点再上班:到达肠道、条件合适时萌发,开始产乳酸、分泌代谢物,参与菌群生态的“人际关系网”。
二、它靠什么发挥:益生菌 + 后生元的“双通道”
我们常把有益微生物叫“益生菌”,而它们在肠道里“产出的好东西”(如有机酸、短肽、多糖等)叫“后生元”。凝结魏茨曼菌的优势是:
1)先活着到场:芽孢帮助“到达率”更稳定;
2)到场能干活:产乳酸,调节局部pH,给“邻居”们创造友好环境;
3)留下作品:其代谢产物(后生元)本身也可能对屏障与微生态有帮助。
请注意——这些都是日常营养与生态层面的讨论,不涉及疾病治疗。
三、为什么和膳食纤维是“黄金搭档”
好菌也要吃饭。可溶性纤维(如魔芋葡甘露聚糖、菊粉、抗性糊精等)是典型的益生元底物。把“菌”和“粮”放在一张餐桌上,往往更容易:
· 让菌群有活儿可干,发酵产生短链脂肪酸(SCFAs);
· 配合纤维的体积/黏度效应,让餐后节律更平缓、饱腹更稳定;
· 在口感上,纤维还能帮配方“增稠顺口”,让你不至于把益生菌当“喝空气”。
四、你关心的三件事:标签、时机、体验
1)看标签:
· 菌名要写全(Weizmannia coagulans 或旧名 Bacillus coagulans);
· 数量怎么标:常见为“每份活菌/芽孢数”,也可能标示为“○○亿/袋”;
· 贮存条件:避光、干燥、阴凉,按说明来。
2)什么时候吃:
· 多数人随餐或餐后更舒服(胃肠反应更小);
· 与含纤维的产品同用,记得配足水;
· 如需与抗菌类药物同日,建议错开(遵医嘱)。
3)期望如何管理:
· 前3–7天可能有短暂胀气/排便性状变化,常见于菌群“磨合期”;
· 体验受作息、饮食结构、运动影响很大——别把“一个菌”当成“全能键”。
五、和你家配方的“队友分工”
· 魔芋粉(葡甘露聚糖):给菌群备好“口粮”,一起把餐后节律拉平;
· 左旋肉碱:负责脂肪酸运输,当总能量与肠道状态更稳,舞台更好发挥;
· 牛磺酸:偏向渗透压与膜稳定,在训练日做“稳场器”;
· GABA:帮助放松—恢复,把深夜“嘴巴管不住”的概率往下按;
· 绿茶粉、山楂、荷叶、决明子、玉竹、茯苓、黄精等:提供清爽风味与多酚背景,让“每天喝”这件事更可持续;
· 维生素B2、烟酸、泛酸钙、维生素D3:一个负责酶系底座,一个照顾骨骼与肌肉,都是“长期主义”的硬件。
六、常见误区:别让好菌背锅
· 误区1:益生菌就等于“通便神器”。
肠道是生态系统,不是开关。饮水、纤维、运动量,都在左右结果。
· 误区2:只要菌多就一定好。
数量只是一个变量,活性、到达率、菌株特性都重要;越多≠越灵。
· 误区3:空腹干吞更猛烈。
有些人空腹更敏感,随餐/餐后可能更舒适。
· 误区4:今天吃、明天判亲疏。
微生态的变化偏“慢工出细活”,建议连续使用并配合生活方式。
七、谁需要更谨慎
· 免疫功能受损、重症、植入医疗器械等人群:使用前请咨询医生;
· 孕产期、慢病或正在用药:建议专业评估;
· 出现持续不适(腹痛、发热等)应暂停并就医。
科普仅用于学习交流,不替代医疗建议。
八、把它放进一日流程的示范
· 早餐:全谷主食 + 蛋白来源 + 蔬果;
· 午餐:按盘分配(蔬菜半盘、主食四分之一、蛋白四分之一);
· 下午/傍晚:有氧+力量的混合训练;
· 益生菌与纤维:按标签安排在随餐/餐后,记得补水;
· 晚间:减少精制糖与油炸;
· 作息:固定入睡与起床时间。
这不是“秒变”的剧本,但它能让菌—粮—作息这套系统真正转起来。
九、小结:把“稳定”当做最大卖点
凝结魏茨曼菌的价值在于稳定到场、在场能干活:它扛得住过程中的风吹雨打,到达肠道后与纤维、作息、运动共同作用,把体验一点点“抚平”。别把它当“特效药”,把它当长期秩序的一部分——这更贴近科学,也更符合现实。
来源: 冀医健康科普中心
科普中国公众号
科普中国微博

帮助
冀医健康科普中心 